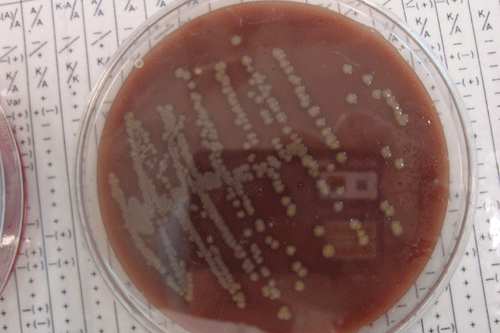

Dutch garden centre fenugreek seeds tested for e-coli
The new Food and Consumer Product Safety Authority (nVWA) has taken samples of fenugreek seeds possibly carrying the EHEC bacteria from two garden centres in the southern Dutch province of Limburg.
Sign in to continue
Need to activate your subscription?
Already a subscriber
If you haven't already, activate your subscription here>>
Company Domain Access
If your company or university has a corporate subscription simply register your email address here to gain access